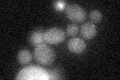
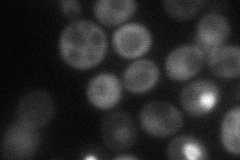

View description
Transcription factor that activates expression of early G1-specific genes, localizes to daughter cell nuclei after cytokinesis and delays G1 progression in daughters, localization is regulated by phosphorylation; potential Cdc28p substrate
Localization:
Intensity:
Fold change:
Significance:
-
C’ GFP library in SD
nucleus21.84 -
N' NOP1pr-GFP in SD

cytosol,nucleus35.797 -
N' TEF2pr-mCherry in SD
cytosol,nucleus40.7651 -
N' NATIVEpr-GFP in SD

cytosol23.7204 -
N' TEF2pr-VC and Cyto-VN in SD

cytosol33.2259 -
C’ GFP library in SD+DTT

nucleus21.650.99No -
C’ GFP library in SD+H2O2

nucleus23.131.05No -
C’ GFP library in Starvation Media

nucleusN/AN/AYes -
C’ GFP library on the background of Pup2-DaMP

nucleus -
C’ GFP library on the background of CCT mutant

nucleus20.75230.949811No
